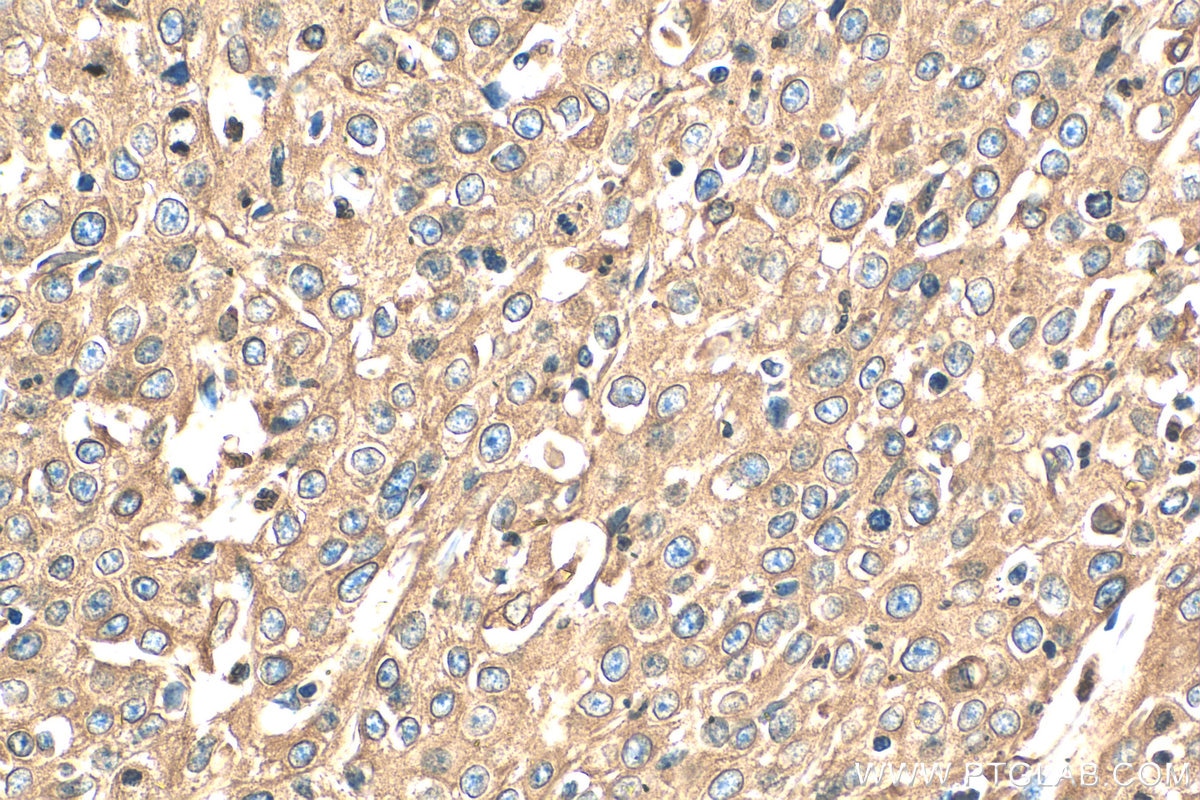
Immunohistochemistry (IHC) staining of human cervical cancer tissue using Calnexin Polyclonal antibody (10427-2-AP)
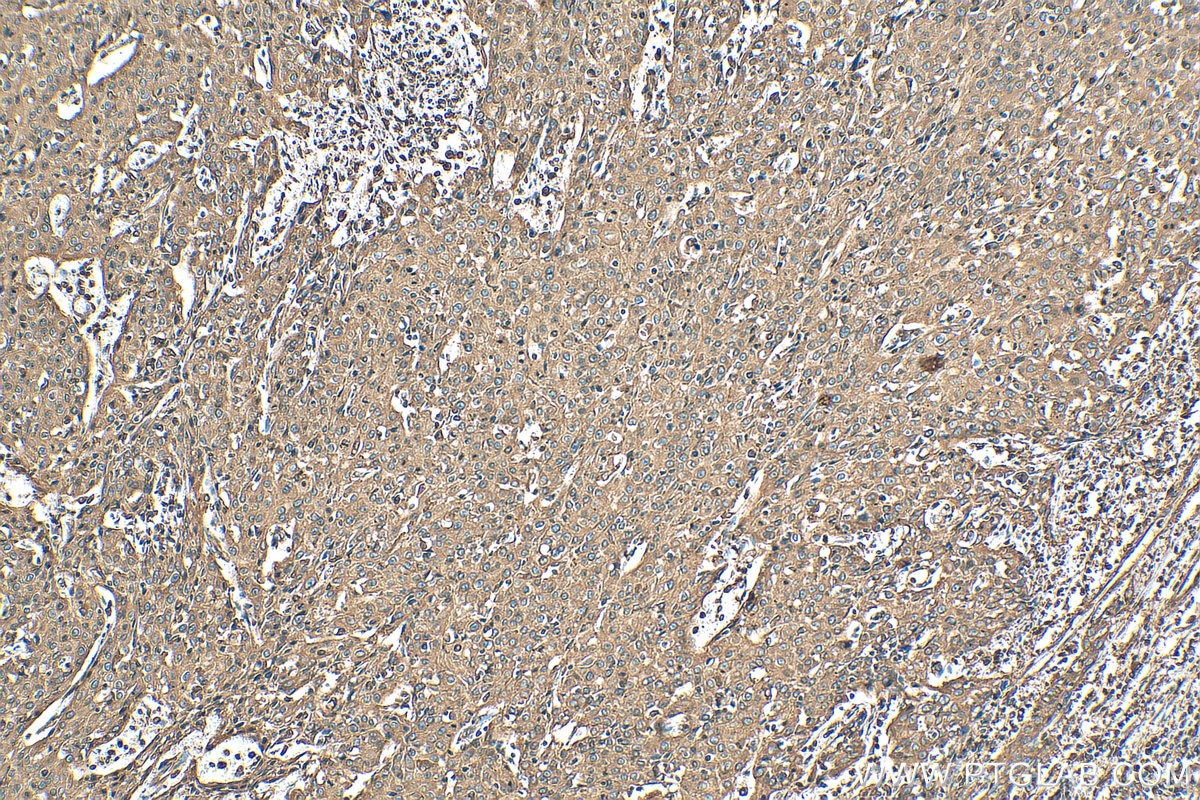
Immunohistochemistry (IHC) staining of human cervical cancer tissue using Calnexin Polyclonal antibody (10427-2-AP)

Tested Applications
| Positive WB detected in | HEK-293 cells, HepG2 cells, HeLa cells, K-562 cells, MCF-7 cells, NIH/3T3 cells, U2OS cells, RAW 264.7 cells |
| Positive IHC detected in | human breast cancer tissue, human cervical cancer tissue, human colon tissue Note: suggested antigen retrieval with TE buffer pH 9.0; (*) Alternatively, antigen retrieval may be performed with citrate buffer pH 6.0 |
| Positive IF/ICC detected in | U2OS cells, HepG2 cells, SKOV-3 cells |
| Positive FC (Intra) detected in | HeLa cells |
Recommended dilution
| Application | Dilution |
|---|---|
| Western Blot (WB) | WB : 1:5000-1:50000 |
| Immunohistochemistry (IHC) | IHC : 1:50-1:500 |
| Immunofluorescence (IF)/ICC | IF/ICC : 1:200-1:800 |
| Flow Cytometry (FC) (INTRA) | FC (INTRA) : 0.20 ug per 10^6 cells in a 100 µl suspension |
| It is recommended that this reagent should be titrated in each testing system to obtain optimal results. | |
| Sample-dependent, Check data in validation data gallery. | |
Published Applications
| WB | See 467 publications below |
| IHC | See 4 publications below |
| IF | See 75 publications below |
| IP | See 1 publications below |
| ELISA | See 1 publications below |
| CoIP | See 1 publications below |
Product Information
10427-2-AP targets Calnexin in WB, IHC, IF/ICC, FC (Intra), IP, CoIP, ELISA applications and shows reactivity with human, mouse, rat samples.
| Tested Reactivity | human, mouse, rat |
| Cited Reactivity | human, mouse, rat, pig, monkey, hamster, goat |
| Host / Isotype | Rabbit / IgG |
| Class | Polyclonal |
| Type | Antibody |
| Immunogen |
CatNo: Ag0697 Product name: Recombinant human Calnexin protein Source: e coli.-derived, PGEX-4T Tag: GST Domain: 1-273 aa of BC003552 Sequence: MEGKWLLCMLLVLGTAIVEAHDGHDDDVIDIEDDLDDVIEEVEDSKPDTTAPPSSPKVTYKAPVPTGEVYFADSFDRGTLSGWILSKAKKDDTDDEIAKYDGKWEVEEMKESKLPGDKGLVLMSRAKHHAISAKLNKPFLFDTKPLIVQYEVNFQNGIECGGAYVKLLSKTPELNLDQFHDKTPYTIMFGPDKCGEDYKLHFIFRHKNPKTGIYEEKHAKRPDADLKTYFTDKKTHLYTLILNPDNSFEILVDQSVVNSGNLLNDMTPPVNPS Predict reactive species |
| Full Name | calnexin |
| Calculated Molecular Weight | 90 kDa |
| Observed Molecular Weight | 90 kDa |
| GenBank Accession Number | BC003552 |
| Gene Symbol | Calnexin |
| Gene ID (NCBI) | 821 |
| RRID | AB_2069033 |
| Conjugate | Unconjugated |
| Form | Liquid |
| Purification Method | Antigen affinity purification |
| UNIPROT ID | P27824 |
| Storage Buffer | PBS with 0.02% sodium azide and 50% glycerol, pH 7.3. |
| Storage Conditions | Store at -20°C. Stable for one year after shipment. Aliquoting is unnecessary for -20oC storage. 20ul sizes contain 0.1% BSA. |
Background Information
Calnexin is a molecular chaperone that resides in the endoplasmic reticulum (ER) and participates in the folding and assembly of newly synthesized proteins. Calnexin is highly abundant in ER and is frequently used as an ER marker.
Protocols
| Product Specific Protocols | |
|---|---|
| FC protocol for Calnexin antibody 10427-2-AP | Download protocol |
| IF protocol for Calnexin antibody 10427-2-AP | Download protocol |
| IHC protocol for Calnexin antibody 10427-2-AP | Download protocol |
| WB protocol for Calnexin antibody 10427-2-AP | Download protocol |
| Standard Protocols | |
|---|---|
| Click here to view our Standard Protocols |
Publications
| Species | Application | Title |
|---|---|---|
Cell Res Mitochondria-localized cGAS suppresses ferroptosis to promote cancer progression | ||
Cell Res Disruption of ER ion homeostasis maintained by an ER anion channel CLCC1 contributes to ALS-like pathologies | ||
Mol Cancer Exosomal circ_0006896 promotes AML progression via interaction with HDAC1 and restriction of antitumor immunity | ||
Cell Discov A RIPK3-independent role of MLKL in suppressing parthanatos promotes immune evasion in hepatocellular carcinoma | ||
Immunity The nucleotide receptor STING translocates to the phagosomes to negatively regulate anti-fungal immunity |
Reviews
The reviews below have been submitted by verified Proteintech customers who received an incentive for providing their feedback.
FH Zakia (Verified Customer) (01-06-2026) | The Calnexin rabbit polyclonal antibody performed excellently in our study using mouse brain samples. The antibody produced a strong and specific signal, with a clearly defined band at approximately 90 kDa, which is consistent with the expected molecular weight of Calnexin. Background signal was minimal, allowing for confident interpretation of results.
![]() |
FH Guo-rong (Verified Customer) (02-06-2023) | Clear bands can be detected in total cell lysates rather than in extracellular vesicles, as a good EV exclusive marker
![]() |
FH Saba (Verified Customer) (03-14-2022) | The band of the antibody was so sharp and specific. The dilution I used was 1:4000 and it worked perfectly.
|
FH Meliti (Verified Customer) (09-25-2019) | 1:1000 dilution in 5%milk PBST O/N incubation for all antibodies depicted which all come from Proteintech 1:5000 anti rabbit HRP in 5%milk PBST for 1h
![]() |